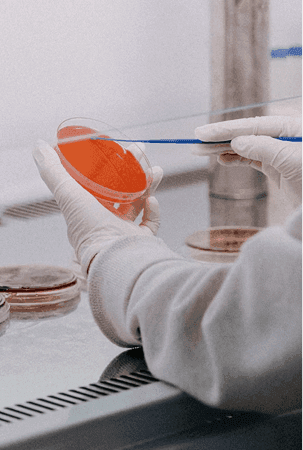
No Animal Tested

We offer a wide array of products for varying demographic and psychographic needs of its users – ENCHANTEUR, ENCHANTEUR CHIC & ENCHANTEUR Luxe.



We offer a wide array of products for varying demographic and psychographic needs of its users – ENCHANTEUR, ENCHANTEUR CHIC & ENCHANTEUR Luxe.

The ladies whom we are speaking to are modern, capable and confident, yet when she is with her partner or someone potential, she would love to receive appreciation and attention for who she is – and she is not afraid to initiate moves to trigger. ENCHANTEUR continues to play its part as your trusted co-conspirator in making every moment special at every knocking opportunity.

Launched in 1989, ENCHANTEUR have evolve together with the modern Malaysian woman, providing quintessentially French-inspired fragrances & toiletries specially curated for women of all stages of life and yet stayed true to its roots.

Natural

Halal

No Animal Tested

Dermatology Tested
Skin Friendly